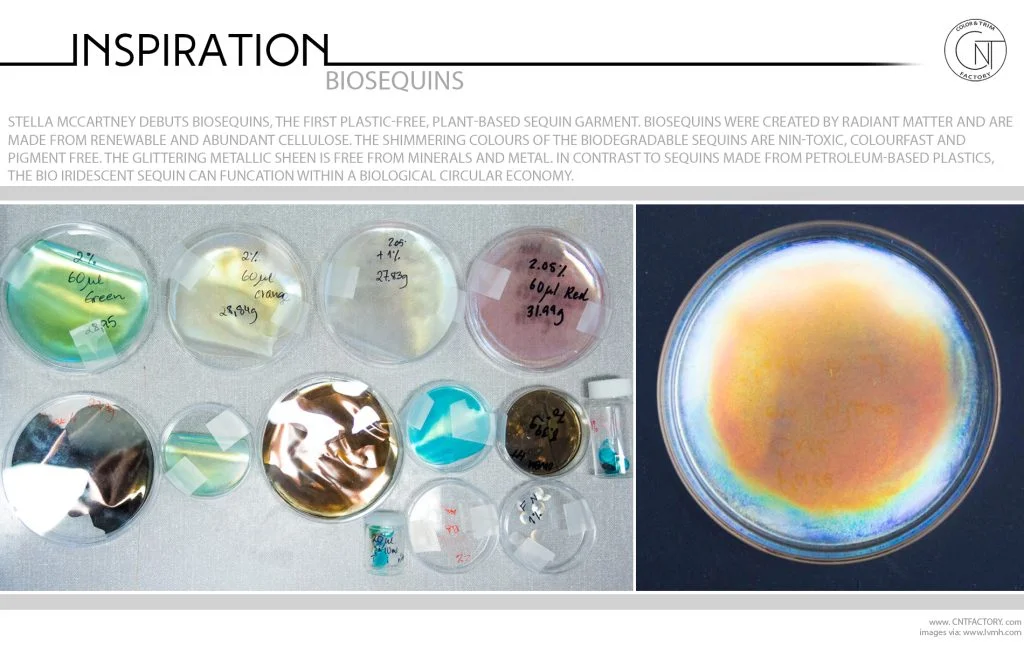
BioSequins

Related Post: Regenerated Nylon ECONYL® / Recycled Plastic by Ecobirdy / Sulapac® Biodegradable Material
Stella McCartney debuts BioSequins, the first plastic-free, plant-based sequin garment. BioSequins were created by Radiant Matter and are made from renewable and abundant cellulose. The shimmering colors of the biodegradable sequins are non-toxic, colorfast and pigment free. The glittering metallic sheen is free from minerals and metal. In contrast to sequins made from petroleum-based plastics, the Bio iridescent sequin can function within a biological circular economy.